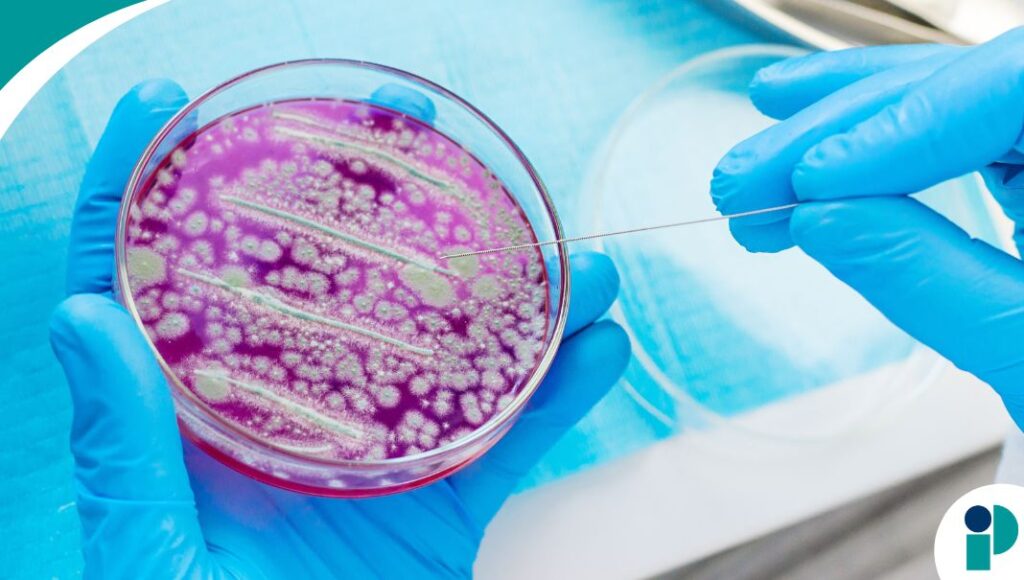
original web (70)

Un estudio reciente ha identificado un posible biomarcador sanguíneo capaz de predecir el riesgo de mortalidad en pacientes con candidemia, una infección fúngica invasiva causada por levaduras del género Candida. La investigación señala que niveles elevados de la citocina Meteorin-like (METRNL) también conocida como interleucina-41, se asocian con un peor pronóstico clínico.
Los hallazgos, publicados en la revista Science Translational Medicine, sugieren que METRNL podría convertirse en una herramienta clave para el manejo de precisión de las infecciones fúngicas, al permitir la estratificación de riesgo y abrir la puerta a enfoques terapéuticos personalizados.
Según los investigadores, METRNL no solo permitiría identificar a los pacientes con mayor riesgo de mortalidad, sino que también podría convertirse en un blanco terapéutico, combinando diagnóstico y tratamiento en un solo enfoque, conocido como teranóstico.
“Nuestro estudio sugiere que la METRNL circulante en sangre podría representar un biomarcador atractivo, previamente no reconocido, para identificar a un grupo de pacientes con mayor riesgo de mortalidad”, señaló Jiayu Liu, PhD, del First Affiliated Hospital of Chongqing Medical University, junto a su equipo de investigación.
Los autores añadieron que, en pacientes humanos con candidemia, las concentraciones iniciales elevadas de METRNL en suero se asociaron con peor supervivencia, lo que refuerza su potencial como marcador pronóstico.
Candidiasis invasiva
La candidiasis invasiva es una infección grave que ocurre cuando las levaduras Candida, habitualmente presentes en la piel y el organismo, proliferan de forma descontrolada y penetran en el torrente sanguíneo o en órganos internos.
Se estima que esta enfermedad afecta a 1.5 millones de personas al año en todo el mundo, con cerca de un millón de muertes, especialmente entre pacientes inmunocomprometidos. A esto se suma la creciente preocupación por la resistencia antifúngica de varias especies de Candida.
Dado que Candida albicans es la principal causa de candidiasis invasiva, los investigadores evaluaron el papel de METRNL mediante estudios en modelos murinos y cohortes humanas.
Los resultados demostraron que METRNL actúa como un regulador clave de la enfermedad, funcionando como un punto de control inmunológico que favorece la infección fúngica invasiva. En modelos animales, los ratones que carecían de esta citocina mostraron protección frente a la infección sistémica por C. albicans.
Asimismo, el bloqueo de METRNL mediante un anticuerpo neutralizante mejoró significativamente la evolución de la infección, mientras que su sobreexpresión agravó la patología fúngica.
Impacto de METRNL sobre la respuesta inmunitaria
Los investigadores encontraron que METRNL inhibe la actividad antifúngica de los macrófagos, células clave del sistema inmunológico. Este efecto ocurre a través del receptor KIT y la vía de señalización STAT3, lo que reduce la expresión del receptor dectin-1, esencial para la fagocitosis y eliminación de las levaduras.
La disminución de dectin-1 compromete la capacidad de los macrófagos para reconocer, ingerir y destruir Candida, facilitando así la progresión de la infección.
En dos cohortes independientes de pacientes con candidemia, se observaron niveles significativamente más altos de METRNL circulante en comparación con pacientes con bacteriemia o voluntarios sanos. En ambos grupos, las concentraciones elevadas de esta citocina se asociaron de manera consistente con menor supervivencia.
Los autores concluyen que METRNL desempeña un rol perjudicial en la fisiopatología de la candidiasis, actuando como un punto de control inmunológico que puede ser inhibido para proteger frente a sepsis fatal por C. albicans. “METRNL emerge como un biomarcador prometedor que podría permitir una evaluación personalizada del riesgo y del pronóstico en pacientes con candidemia”, señalaron los investigadores.
Estos hallazgos abren nuevas posibilidades para el diagnóstico temprano, la estratificación de riesgo y el desarrollo de terapias dirigidas, en un contexto donde las infecciones fúngicas invasivas continúan representando un importante desafío para la salud pública global.
Fuente original aquí

![portada nota[1]](https://phlatames.com/wp-content/uploads/2025/03/portada-nota1-300x169.png)






